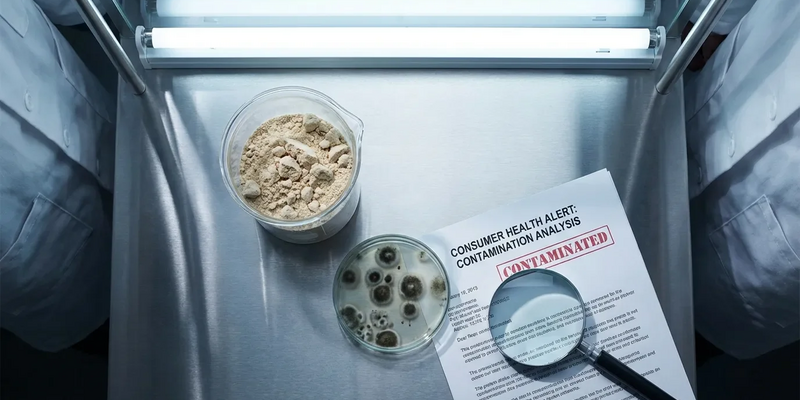
Stiftung Warentest: Schimmelpilze in Diät-Shakes entdeckt - Foto: über boerse-global.de

Stiftung Warentest: Schimmelpilze in Diät-Shakes entdeckt
08.01.2026 - 21:22:12Die Stiftung Warentest rügt Mahlzeitersatz-Shakes als schadstoffbelastet. Nur zwei von 20 getesteten Pulvern schneiden gut ab, einige enthalten sogar Schimmelpilze und Bakterien. Teure Apothekenmarken enttäuschen.
Die aktuelle Untersuchung (01/2026) der Verbraucherschützer fällt vernichtend aus. Lediglich der Optifast Drink von Nestlé (Note 2,4) und der Layenberger Fit+Feelgood Slim Shake (Note 2,5) erreichen das Urteil „Gut“. Die große Mehrheit der Vanille-Shakes aus Drogerie, Supermarkt und Apotheke fällt durch – mit Noten bis hin zu „Mangelhaft“.
Chlorat‑Funde in einigen Mahlzeitersatz‑Shakes können die Jodaufnahme stören und damit Schilddrüsenwerte wie das TSH verfälschen – das kann zu Fehldiagnosen führen, wenn Sie regelmäßig solche Produkte konsumieren. Wer seine Blutwerte sinnvoll interpretiert, trifft bessere Entscheidungen zu Ernährung und möglichen Nachtests. Ein kostenloser 25‑Seiten‑Report erklärt verständlich, welche Laborwerte (z. B. TSH, Cholesterin, wichtige Vitalstoffe) wirklich relevant sind, welche Spezialtests sinnvoll sein können und wann Sie Ihren Arzt auf zusätzliche Untersuchungen ansprechen sollten. Laborwerte verstehen & Gratis‑Report anfordern
Alarm im Pulver: Keime und Chlorat
Besorgniserregend sind die mikrobiologischen und chemischen Funde. In einigen Produkten stießen die Tester auf kritische Verunreinigungen.
- Hygienemängel: Im Shake von Trinkkost wiesen die Prüfer eine zu hohe Anzahl an Enterobakterien nach. Diese Keime deuten auf Probleme in der Produktionshygiene hin. In anderen Proben fanden sich Schimmelpilze.
- Chemische Belastung: Hohe Gehalte an Chlorat entdeckten die Tester unter anderem bei Apoday Slim und Formoline. Dieser Stoff kann die Jodaufnahme der Schilddrüse blockieren und stellt besonders bei regelmäßigem Verzehr eine unnötige Belastung dar.
Teure Marken floppen im Test
Eine bittere Pille für viele Verbraucher: Die teuren Platzhirsche der Branche liegen nur im Mittelfeld. Die bekannten Marken Almased und Yokebe schnitten lediglich mit „Ausreichend“ ab. Neben geschmacklichen Mängeln und undurchsichtiger Deklaration sorgten auch hier bedenkliche Inhaltsstoffe für die Abwertung.
Der Test entlarvt den Mythos vom teuren Qualitätsprodukt. Eine Portion Almased kostet bis zu 2,22 Euro – der Testsieger von Layenberger ist oft deutlich günstiger zu haben.
Kennzeichnung: Fast jedes zweite Pulver patzt
Ein weiterer Kritikpunkt ist das Chaos bei der Deklaration. „Formula-Diäten“ unterliegen strengen Nährstoffvorgaben. Doch fast jedes zweite Produkt hielt sich nicht an die Pflichtangaben oder machte irreführende Werbeversprechen. Angesichts drohender schärferer EU-Vorgaben müssen die Hersteller hier dringend nachbessern.
Was bedeutet das für Verbraucher?
Die Ergebnisse treffen die Branche im umsatzstärksten Monat des Jahres. Ernährungsexperten sehen ihre Skepsis bestätigt: Die Shakes sind hochverarbeitete Industrieprodukte und kein Ersatz für eine echte Ernährungsumstellung.
Wer dennoch nicht auf Pulver-Diäten verzichten möchte, sollte sich an die Testsieger halten. Wegen der möglichen Schadstoffanreicherung raten Experten davon ab, die Shakes dauerhaft zu konsumieren. Die sicherste Alternative bleibt unverarbeitetes Essen wie Gemüse, Vollkorn und mageres Protein.